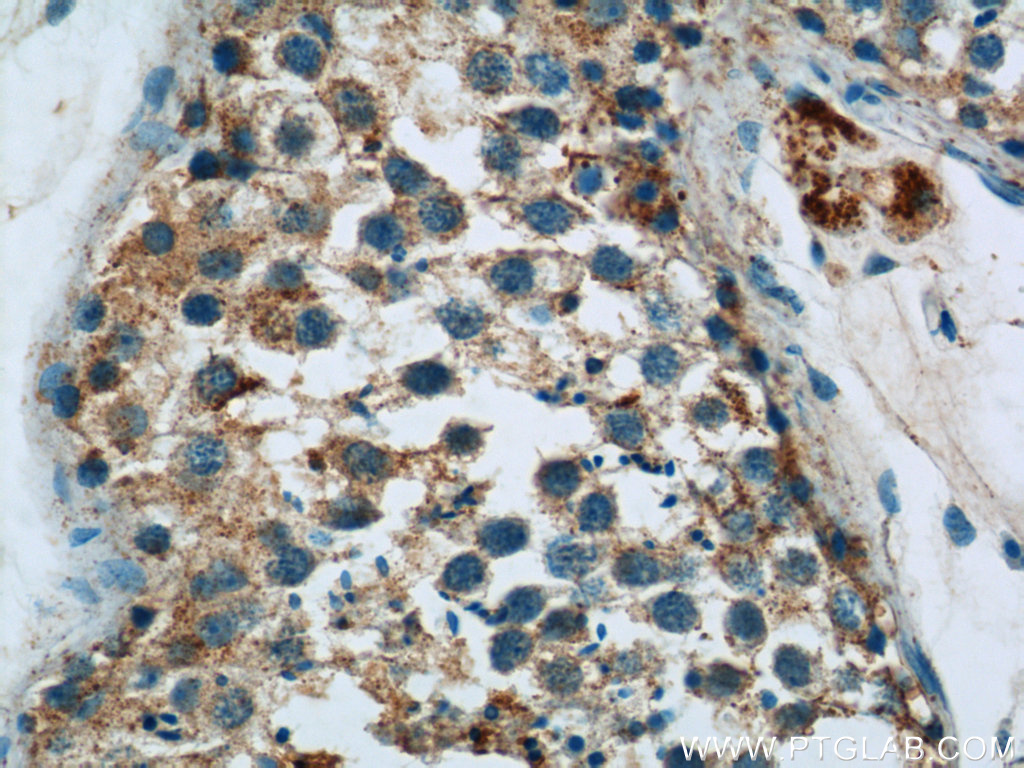

HYAL4抗体
产品名称: HYAL4抗体
英文名称: HYAL4Antibody
产品编号: XY18139-1
产品价格: null
产品产地: 中国/美国
品牌商标: XYbscience
更新时间: 2023-08-17T09:55:27
使用范围: WB,ELISA,IHC-P,IHC-F,IF
- 联系人 : 徐经理
- 地址 : 上海市闵行莘庄工业区春东路508号A1-2F
- 邮编 : 200612
- 所在区域 : 上海
- 电话 : 152****8802 点击查看
- 传真 : 点击查看
- 邮箱 : shxysw02@163.com
- 二维码 : 点击查看
HYAL4抗体
IP = Immunoprecipitation
XY798Ra21 核受体共激活因子3(NCOA3)单克隆抗体 Monoclonal Antibody to Nuclear Receptor Coactivator 3 (NCOA3) Rattus norvegicus (Rat)
XY801Hu21 AMPA离子能谷氨酸受体1(GRIA1)单克隆抗体 Monoclonal Antibody to Glutakle Receptor, Ionotropic, AMPA 1 (GRIA1) Homo sapiens (Hukl)
XY801Ra21 AMPA离子能谷氨酸受体1(GRIA1)单克隆抗体 Monoclonal Antibody to Glutakle Receptor, Ionotropic, AMPA 1 (GRIA1) Rattus norvegicus (Rat)
XY802Hu21 AMPA离子能谷氨酸受体2(GRIA2)单克隆抗体 Monoclonal Antibody to Glutakle Receptor, Ionotropic, AMPA 2 (GRIA2) Homo sapiens (Hukl)
XY803Hu21 AMPA离子能谷氨酸受体3(GRIA3)单克隆抗体 Monoclonal Antibody to Glutakle Receptor, Ionotropic, AMPA 3 (GRIA3) Homo sapiens (Hukl)
XY804Hu21 AMPA离子能谷氨酸受体4(GRIA4)单克隆抗体 Monoclonal Antibody to Glutakle Receptor, Ionotropic, AMPA 4 (GRIA4) Homo sapiens (Hukl)
XY805Ra21 N-甲基-D-天氡氨酸离子能谷氨酸受体1(GRIN1)单克隆抗体 Monoclonal Antibody to Glutakle Receptor, Ionotropic, N-Methyl-D-Aspartate 1 (GRIN1) Rattus norvegicus (Rat)
XY806Hu21 N-甲基-D-天氡氨酸离子能谷氨酸受体2A(GRIN2A)单克隆抗体 Monoclonal Antibody to Glutakle Receptor, Ionotropic, N-Methyl-D-Aspartate 2A (GRIN2A) Homo sapiens (Hukl)
XY807Hu21 N-甲基-D-天氡氨酸离子能谷氨酸受体2B(GRIN2B)单克隆抗体 Monoclonal Antibody to Glutakle Receptor, Ionotropic, N-Methyl-D-Aspartate 2B (GRIN2B) Homo sapiens (Hukl)
XY808Hu21 N-甲基-D-天氡氨酸离子能谷氨酸受体2C(GRIN2C)单克隆抗体 Monoclonal Antibody to Glutakle Receptor, Ionotropic, N-Methyl-D-Aspartate 2C (GRIN2C) Homo sapiens (Hukl)
XY809Hu21 N-甲基-D-天氡氨酸离子能谷氨酸受体2D(GRIN2D)单克隆抗体 Monoclonal Antibody to Glutakle Receptor, Ionotropic, N-Methyl-D-Aspartate 2D (GRIN2D) Homo sapiens (Hukl)
XY821Hu21 代谢型型谷氨酸受体1(GRM1)单克隆抗体 Monoclonal Antibody to Glutakle Receptor, Metabotropic 1 (GRM1) Homo sapiens (Hukl)
XY824Hu21 醛脱氢酶1家族成员A1(ALDH1A1)单克隆抗体 Monoclonal Antibody to Aldehyde Dehydrogenase 1 Family, Member A1 (ALDH1A1) Homo sapiens (Hukl)
XY825Hu21 醛脱氢酶1家族成员A2(ALDH1A2)单克隆抗体 Monoclonal Antibody to Aldehyde Dehydrogenase 1 Family, Member A2 (ALDH1A2) Homo sapiens (Hukl)
XY830Hu21 醛脱氢酶3家族成员A1(ALDH3A1)单克隆抗体 Monoclonal Antibody to Aldehyde Dehydrogenase 3 Family, Member A1 (ALDH3A1) Homo sapiens (Hukl)
XY843Hu21 白介素1ε(IL1ε)单克隆抗体 Monoclonal Antibody to Interleukin 1 Epsilon (IL1e) Homo sapiens (Hukl)